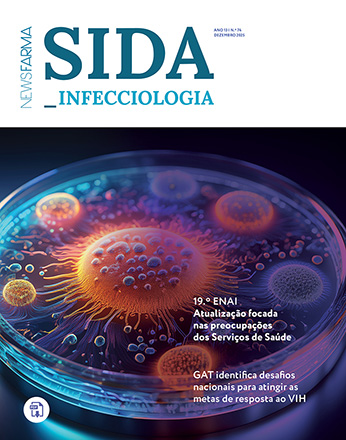
SIDA_Infecciologia n.º 74, dezembro 2025

Encontros da Primavera 2026, n.º2
17 Abril, 2026

17 Abril, 2026

17 Abril, 2026
01 Abril, 2026

24 Março, 2026

23 Março, 2026

06 Março, 2026

06 Março, 2026

25 Fevereiro, 2026

31 Janeiro, 2026

30 Janeiro, 2026

29 Janeiro, 2026

29 Janeiro, 2026
30 Dezembro, 2025

26 Dezembro, 2025

23 Dezembro, 2025

19 Dezembro, 2025

31 Outubro, 2025

31 Outubro, 2025
30 Outubro, 2025

30 Setembro, 2025
24 Setembro, 2025

22 Setembro, 2025

11 Setembro, 2025

26 Junho, 2025

26 Junho, 2025

25 Junho, 2025

25 Junho, 2025

04 Abril, 2025

03 Abril, 2025

30 Março, 2025
28 Março, 2025

28 Março, 2025

12 Março, 2025

08 Março, 2025

07 Março, 2025

20 Fevereiro, 2025

31 Janeiro, 2025

31 Janeiro, 2025

24 Janeiro, 2025

31 Dezembro, 2024
31 Dezembro, 2024

20 Dezembro, 2024

09 Dezembro, 2024
15 Outubro, 2024

26 Setembro, 2024

18 Setembro, 2024
18 Setembro, 2024
18 Setembro, 2024

27 Junho, 2024
26 Junho, 2024

18 Junho, 2024

06 Maio, 2024

12 Abril, 2024

11 Abril, 2024
08 Abril, 2024

04 Abril, 2024

09 Março, 2024

08 Março, 2024

06 Março, 2024

03 Fevereiro, 2024

02 Fevereiro, 2024

26 Janeiro, 2024

05 Janeiro, 2024
04 Janeiro, 2024

04 Janeiro, 2024

20 Dezembro, 2023
20 Novembro, 2023

02 Novembro, 2023

02 Novembro, 2023

10 Outubro, 2023

10 Outubro, 2023
22 Setembro, 2023

12 Setembro, 2023

12 Setembro, 2023
14 Julho, 2023

28 Junho, 2023

28 Junho, 2023

16 Junho, 2023

15 Junho, 2023

29 Maio, 2023

22 Maio, 2023

03 Maio, 2023

03 Maio, 2023

16 Abril, 2023

15 Abril, 2023

14 Abril, 2023
05 Abril, 2023

05 Abril, 2023

24 Março, 2023

17 Março, 2023

15 Março, 2023

08 Março, 2023

08 Março, 2023

10 Fevereiro, 2023

04 Fevereiro, 2023

03 Fevereiro, 2023
16 Janeiro, 2023

29 Dezembro, 2022

22 Dezembro, 2022

22 Dezembro, 2022

30 Novembro, 2022

28 Novembro, 2022

26 Novembro, 2022

07 Novembro, 2022

15 Outubro, 2022

14 Outubro, 2022

14 Outubro, 2022

12 Outubro, 2022

22 Setembro, 2022

16 Agosto, 2022
16 Agosto, 2022

01 Agosto, 2022

01 Agosto, 2022

13 Julho, 2022

24 Junho, 2022

23 Junho, 2022

14 Junho, 2022

03 Junho, 2022

02 Junho, 2022

02 Junho, 2022

25 Maio, 2022

25 Maio, 2022

11 Maio, 2022

29 Abril, 2022

27 Abril, 2022

24 Abril, 2022

23 Abril, 2022

22 Abril, 2022

13 Abril, 2022

12 Abril, 2022

01 Abril, 2022
22 Março, 2022

11 Março, 2022

10 Março, 2022

02 Março, 2022

02 Março, 2022

25 Fevereiro, 2022

24 Fevereiro, 2022

24 Fevereiro, 2022

05 Fevereiro, 2022

04 Fevereiro, 2022

30 Dezembro, 2021

21 Dezembro, 2021

21 Dezembro, 2021

13 Dezembro, 2021

07 Dezembro, 2021

27 Novembro, 2021

25 Novembro, 2021

25 Novembro, 2021

24 Novembro, 2021

02 Novembro, 2021

22 Outubro, 2021

10 Setembro, 2021

09 Setembro, 2021

06 Setembro, 2021

18 Agosto, 2021

18 Agosto, 2021

05 Julho, 2021

16 Junho, 2021

16 Junho, 2021

07 Junho, 2021

07 Junho, 2021

07 Junho, 2021

26 Maio, 2021

30 Abril, 2021

30 Abril, 2021

27 Março, 2021

27 Março, 2021

27 Março, 2021

27 Março, 2021

12 Março, 2021

14 Janeiro, 2021

12 Janeiro, 2021

12 Janeiro, 2021

12 Janeiro, 2021

12 Janeiro, 2021

12 Janeiro, 2021

12 Janeiro, 2021

12 Janeiro, 2021

12 Janeiro, 2021

12 Janeiro, 2021

07 Janeiro, 2021

07 Janeiro, 2021

07 Janeiro, 2021

05 Dezembro, 2020

24 Novembro, 2020

23 Novembro, 2020

05 Novembro, 2020

03 Outubro, 2020

01 Setembro, 2020

16 Julho, 2020

16 Julho, 2020

16 Julho, 2020

16 Julho, 2020

16 Julho, 2020

14 Julho, 2020

20 Maio, 2020

18 Maio, 2020

12 Maio, 2020

12 Maio, 2020

17 Março, 2020

09 Março, 2020

07 Março, 2020

06 Março, 2020

02 Março, 2020

28 Fevereiro, 2020

28 Fevereiro, 2020

20 Fevereiro, 2020

19 Fevereiro, 2020

19 Fevereiro, 2020

14 Fevereiro, 2020

14 Fevereiro, 2020

29 Janeiro, 2020

24 Janeiro, 2020

24 Janeiro, 2020

24 Janeiro, 2020

23 Janeiro, 2020

23 Janeiro, 2020

17 Janeiro, 2020

16 Janeiro, 2020

09 Janeiro, 2020

09 Janeiro, 2020

09 Janeiro, 2020

09 Janeiro, 2020

09 Janeiro, 2020

09 Janeiro, 2020

09 Janeiro, 2020

09 Janeiro, 2020

09 Janeiro, 2020

09 Janeiro, 2020

08 Janeiro, 2020

08 Janeiro, 2020

08 Janeiro, 2020

16 Dezembro, 2019

12 Dezembro, 2019

06 Dezembro, 2019

29 Novembro, 2019

22 Novembro, 2019

22 Novembro, 2019

22 Novembro, 2019

21 Novembro, 2019

20 Novembro, 2019

15 Novembro, 2019

15 Novembro, 2019

08 Novembro, 2019

08 Novembro, 2019

24 Outubro, 2019

24 Outubro, 2019

24 Outubro, 2019

23 Outubro, 2019

23 Outubro, 2019

23 Outubro, 2019

11 Outubro, 2019

11 Outubro, 2019

11 Outubro, 2019

03 Outubro, 2019

03 Outubro, 2019

02 Outubro, 2019

09 Agosto, 2019

02 Agosto, 2019

01 Agosto, 2019

01 Agosto, 2019

01 Agosto, 2019

28 Junho, 2019

28 Junho, 2019

28 Junho, 2019

27 Junho, 2019
27 Junho, 2019

21 Junho, 2019

17 Junho, 2019

14 Junho, 2019

01 Junho, 2019

31 Maio, 2019

31 Maio, 2019

30 Maio, 2019

30 Maio, 2019

28 Maio, 2019

27 Maio, 2019

23 Maio, 2019

23 Maio, 2019

17 Maio, 2019

09 Maio, 2019

09 Maio, 2019

09 Maio, 2019

02 Maio, 2019

29 Abril, 2019

28 Abril, 2019

27 Abril, 2019

27 Abril, 2019

26 Abril, 2019

15 Abril, 2019

15 Abril, 2019

13 Abril, 2019

12 Abril, 2019

29 Março, 2019

29 Março, 2019

26 Março, 2019

10 Março, 2019

09 Março, 2019

08 Março, 2019

08 Março, 2019

07 Março, 2019

07 Março, 2019

22 Fevereiro, 2019

07 Fevereiro, 2019

30 Janeiro, 2019

29 Janeiro, 2019

25 Janeiro, 2019

25 Janeiro, 2019

25 Janeiro, 2019

18 Janeiro, 2019

17 Janeiro, 2019

17 Janeiro, 2019

03 Janeiro, 2019

21 Dezembro, 2018
14 Dezembro, 2018

07 Dezembro, 2018

05 Dezembro, 2018

01 Dezembro, 2018

30 Novembro, 2018

29 Novembro, 2018

24 Novembro, 2018

23 Novembro, 2018

23 Novembro, 2018

23 Novembro, 2018

23 Novembro, 2018

21 Novembro, 2018

21 Novembro, 2018

16 Novembro, 2018

15 Novembro, 2018

09 Novembro, 2018

09 Novembro, 2018

02 Novembro, 2018

02 Novembro, 2018
02 Novembro, 2018

25 Outubro, 2018

25 Outubro, 2018

18 Outubro, 2018

12 Outubro, 2018

12 Outubro, 2018

12 Outubro, 2018

10 Outubro, 2018

27 Setembro, 2018

26 Setembro, 2018

21 Setembro, 2018

20 Setembro, 2018

07 Setembro, 2018

05 Setembro, 2018

04 Setembro, 2018

17 Agosto, 2018

17 Agosto, 2018

17 Agosto, 2018

09 Agosto, 2018

01 Agosto, 2018

26 Julho, 2018

26 Julho, 2018

25 Julho, 2018

13 Julho, 2018

11 Julho, 2018

09 Julho, 2018

06 Julho, 2018

02 Julho, 2018

29 Junho, 2018

28 Junho, 2018

23 Junho, 2018

22 Junho, 2018

21 Junho, 2018

20 Junho, 2018

18 Junho, 2018
18 Junho, 2018

15 Junho, 2018

05 Junho, 2018

05 Junho, 2018

28 Maio, 2018

25 Maio, 2018

18 Maio, 2018

17 Maio, 2018

11 Maio, 2018

08 Maio, 2018

01 Maio, 2018

30 Abril, 2018

29 Abril, 2018

28 Abril, 2018

26 Abril, 2018

23 Abril, 2018

20 Abril, 2018

20 Abril, 2018

14 Abril, 2018

13 Abril, 2018

09 Abril, 2018

09 Abril, 2018

06 Abril, 2018

06 Abril, 2018

06 Abril, 2018

06 Abril, 2018

06 Abril, 2018

06 Abril, 2018

06 Abril, 2018

02 Abril, 2018

02 Abril, 2018

02 Abril, 2018

23 Março, 2018

12 Março, 2018

08 Março, 2018

08 Março, 2018

08 Março, 2018

02 Março, 2018

02 Março, 2018

22 Fevereiro, 2018

16 Fevereiro, 2018

09 Fevereiro, 2018

05 Fevereiro, 2018

02 Fevereiro, 2018

26 Janeiro, 2018

25 Janeiro, 2018

25 Janeiro, 2018

19 Janeiro, 2018

18 Janeiro, 2018

15 Janeiro, 2018

12 Janeiro, 2018

10 Janeiro, 2018

22 Dezembro, 2017

28 Novembro, 2017

24 Novembro, 2017

24 Novembro, 2017

24 Novembro, 2017

24 Novembro, 2017

23 Novembro, 2017

22 Novembro, 2017

17 Novembro, 2017

16 Novembro, 2017

10 Novembro, 2017

10 Novembro, 2017

09 Novembro, 2017

06 Novembro, 2017

03 Novembro, 2017

27 Outubro, 2017

27 Outubro, 2017

27 Outubro, 2017

25 Outubro, 2017

23 Outubro, 2017

13 Outubro, 2017

13 Outubro, 2017

12 Outubro, 2017

10 Outubro, 2017

06 Outubro, 2017

26 Setembro, 2017

05 Setembro, 2017

05 Setembro, 2017

24 Agosto, 2017

03 Agosto, 2017

03 Agosto, 2017

14 Julho, 2017

14 Julho, 2017

13 Julho, 2017

07 Julho, 2017

05 Julho, 2017

30 Junho, 2017

30 Junho, 2017

30 Junho, 2017

29 Junho, 2017

26 Junho, 2017

21 Junho, 2017

21 Junho, 2017

20 Junho, 2017

20 Junho, 2017

20 Junho, 2017

20 Junho, 2017

16 Junho, 2017

02 Junho, 2017

31 Maio, 2017

31 Maio, 2017

26 Maio, 2017

25 Maio, 2017

24 Maio, 2017

22 Maio, 2017

19 Maio, 2017

11 Maio, 2017

05 Maio, 2017

03 Maio, 2017

02 Maio, 2017

02 Maio, 2017

26 Abril, 2017

26 Abril, 2017

26 Abril, 2017

26 Abril, 2017

24 Abril, 2017

21 Abril, 2017

21 Abril, 2017

12 Abril, 2017

12 Abril, 2017

06 Abril, 2017

05 Abril, 2017

31 Março, 2017

28 Março, 2017

23 Março, 2017

13 Março, 2017

10 Março, 2017

10 Março, 2017

10 Março, 2017

10 Março, 2017

08 Março, 2017

07 Março, 2017

07 Março, 2017

06 Março, 2017

22 Fevereiro, 2017

22 Fevereiro, 2017

21 Fevereiro, 2017

10 Fevereiro, 2017

09 Fevereiro, 2017

03 Fevereiro, 2017

03 Fevereiro, 2017

03 Fevereiro, 2017

26 Janeiro, 2017

20 Janeiro, 2017

20 Janeiro, 2017

19 Janeiro, 2017

13 Janeiro, 2017

09 Janeiro, 2017

06 Janeiro, 2017

30 Dezembro, 2016

19 Dezembro, 2016

14 Dezembro, 2016

14 Dezembro, 2016

14 Dezembro, 2016

14 Dezembro, 2016

09 Dezembro, 2016

02 Dezembro, 2016

30 Novembro, 2016

30 Novembro, 2016

24 Novembro, 2016

24 Novembro, 2016

24 Novembro, 2016

24 Novembro, 2016

23 Novembro, 2016

18 Novembro, 2016

18 Novembro, 2016

18 Novembro, 2016

17 Novembro, 2016

10 Novembro, 2016

09 Novembro, 2016

07 Novembro, 2016

04 Novembro, 2016

04 Novembro, 2016

04 Novembro, 2016

03 Novembro, 2016

02 Novembro, 2016

02 Novembro, 2016

27 Outubro, 2016

24 Outubro, 2016

21 Outubro, 2016

21 Outubro, 2016

21 Outubro, 2016

14 Outubro, 2016

13 Outubro, 2016

13 Outubro, 2016

13 Outubro, 2016

23 Setembro, 2016

12 Setembro, 2016

12 Setembro, 2016

07 Setembro, 2016

07 Setembro, 2016

30 Agosto, 2016

30 Agosto, 2016

30 Agosto, 2016

29 Julho, 2016

27 Julho, 2016

14 Julho, 2016

12 Julho, 2016

04 Julho, 2016

04 Julho, 2016

01 Julho, 2016

21 Junho, 2016

16 Junho, 2016

16 Junho, 2016

16 Junho, 2016

09 Junho, 2016

30 Maio, 2016

30 Maio, 2016

27 Maio, 2016

16 Maio, 2016

16 Maio, 2016

13 Maio, 2016

13 Maio, 2016

10 Maio, 2016

09 Maio, 2016

04 Maio, 2016

02 Maio, 2016

25 Abril, 2016

24 Abril, 2016

23 Abril, 2016

22 Abril, 2016

22 Abril, 2016

21 Abril, 2016

19 Abril, 2016

19 Abril, 2016

19 Abril, 2016

18 Abril, 2016

15 Abril, 2016

12 Abril, 2016

08 Abril, 2016

08 Abril, 2016

01 Abril, 2016

31 Março, 2016

31 Março, 2016

28 Março, 2016

19 Março, 2016

18 Março, 2016

18 Março, 2016

17 Março, 2016

11 Março, 2016

11 Março, 2016

11 Março, 2016

08 Março, 2016

08 Março, 2016

08 Março, 2016

04 Março, 2016

04 Março, 2016

26 Fevereiro, 2016

26 Fevereiro, 2016

19 Fevereiro, 2016

12 Fevereiro, 2016

12 Fevereiro, 2016

05 Fevereiro, 2016

05 Fevereiro, 2016

04 Fevereiro, 2016

04 Fevereiro, 2016

01 Fevereiro, 2016

29 Janeiro, 2016

29 Janeiro, 2016

29 Janeiro, 2016

29 Janeiro, 2016

28 Janeiro, 2016

28 Janeiro, 2016

27 Janeiro, 2016

22 Janeiro, 2016

21 Janeiro, 2016

20 Janeiro, 2016

18 Janeiro, 2016

18 Janeiro, 2016

18 Janeiro, 2016

07 Janeiro, 2016

06 Janeiro, 2016

28 Dezembro, 2015

23 Dezembro, 2015

27 Novembro, 2015

27 Novembro, 2015

25 Novembro, 2015

20 Novembro, 2015

20 Novembro, 2015

20 Novembro, 2015

20 Novembro, 2015

19 Novembro, 2015

19 Novembro, 2015

18 Novembro, 2015

16 Novembro, 2015

13 Novembro, 2015

13 Novembro, 2015

13 Novembro, 2015

13 Novembro, 2015

07 Novembro, 2015

06 Novembro, 2015

06 Novembro, 2015

06 Novembro, 2015

06 Novembro, 2015

04 Novembro, 2015

23 Outubro, 2015

22 Outubro, 2015

20 Outubro, 2015

20 Outubro, 2015

20 Outubro, 2015

20 Outubro, 2015

20 Outubro, 2015

20 Outubro, 2015

20 Outubro, 2015

19 Outubro, 2015

16 Outubro, 2015

16 Outubro, 2015

15 Outubro, 2015

15 Outubro, 2015

15 Outubro, 2015

14 Outubro, 2015

24 Setembro, 2015

11 Setembro, 2015

02 Setembro, 2015

02 Setembro, 2015

07 Agosto, 2015

07 Agosto, 2015

31 Julho, 2015

21 Julho, 2015

15 Julho, 2015

14 Julho, 2015

07 Julho, 2015

03 Julho, 2015

25 Junho, 2015

24 Junho, 2015

24 Junho, 2015

23 Junho, 2015

12 Junho, 2015

11 Junho, 2015

09 Junho, 2015

05 Junho, 2015

29 Maio, 2015

29 Maio, 2015

28 Maio, 2015

27 Maio, 2015

27 Maio, 2015

27 Maio, 2015

22 Maio, 2015

22 Maio, 2015

20 Maio, 2015

20 Maio, 2015

15 Maio, 2015

15 Maio, 2015

14 Maio, 2015

11 Maio, 2015

08 Maio, 2015

25 Abril, 2015

24 Abril, 2015

23 Abril, 2015

22 Abril, 2015

20 Abril, 2015

20 Abril, 2015

14 Abril, 2015

10 Abril, 2015

08 Abril, 2015

08 Abril, 2015

07 Abril, 2015

31 Março, 2015

31 Março, 2015

31 Março, 2015

26 Março, 2015

13 Março, 2015

13 Março, 2015

13 Março, 2015

05 Março, 2015

04 Março, 2015

27 Fevereiro, 2015

24 Fevereiro, 2015

24 Fevereiro, 2015

20 Fevereiro, 2015

19 Fevereiro, 2015

19 Fevereiro, 2015

19 Fevereiro, 2015

18 Fevereiro, 2015

13 Fevereiro, 2015

06 Fevereiro, 2015

06 Fevereiro, 2015

30 Janeiro, 2015

29 Janeiro, 2015

29 Janeiro, 2015

28 Janeiro, 2015

28 Janeiro, 2015

27 Janeiro, 2015

27 Janeiro, 2015

27 Janeiro, 2015

24 Janeiro, 2015

23 Janeiro, 2015

23 Janeiro, 2015

23 Janeiro, 2015

22 Janeiro, 2015

22 Janeiro, 2015

31 Dezembro, 2014

31 Dezembro, 2014

11 Dezembro, 2014

03 Dezembro, 2014

03 Dezembro, 2014

03 Dezembro, 2014

28 Novembro, 2014

28 Novembro, 2014

21 Novembro, 2014

21 Novembro, 2014

20 Novembro, 2014

19 Novembro, 2014

14 Novembro, 2014

13 Novembro, 2014

07 Novembro, 2014

07 Novembro, 2014

07 Novembro, 2014

07 Novembro, 2014

06 Novembro, 2014

06 Novembro, 2014

24 Outubro, 2014

17 Outubro, 2014

17 Outubro, 2014

17 Outubro, 2014

16 Outubro, 2014

15 Outubro, 2014

15 Outubro, 2014

10 Outubro, 2014

09 Outubro, 2014

09 Outubro, 2014

03 Outubro, 2014

03 Outubro, 2014

25 Setembro, 2014

29 Agosto, 2014

28 Agosto, 2014

28 Agosto, 2014

28 Agosto, 2014

28 Agosto, 2014

28 Agosto, 2014

28 Agosto, 2014

01 Agosto, 2014

01 Agosto, 2014

24 Julho, 2014

24 Julho, 2014

15 Julho, 2014

15 Julho, 2014

11 Julho, 2014

04 Julho, 2014

01 Julho, 2014

01 Julho, 2014

27 Junho, 2014

20 Junho, 2014

20 Junho, 2014

16 Junho, 2014

06 Junho, 2014

06 Junho, 2014

30 Maio, 2014

23 Maio, 2014

22 Maio, 2014

22 Maio, 2014

20 Maio, 2014

16 Maio, 2014

16 Maio, 2014

16 Maio, 2014

05 Maio, 2014

28 Abril, 2014

08 Abril, 2014

02 Abril, 2014

29 Março, 2014

28 Março, 2014

28 Março, 2014

21 Março, 2014

14 Março, 2014

14 Março, 2014

13 Março, 2014

13 Março, 2014

10 Março, 2014

09 Março, 2014

08 Março, 2014

07 Março, 2014

07 Março, 2014

06 Março, 2014

06 Março, 2014

03 Março, 2014

28 Fevereiro, 2014

07 Fevereiro, 2014

07 Fevereiro, 2014

07 Fevereiro, 2014

31 Janeiro, 2014

31 Janeiro, 2014

30 Janeiro, 2014

30 Janeiro, 2014

29 Janeiro, 2014

26 Janeiro, 2014

25 Janeiro, 2014

24 Janeiro, 2014

24 Janeiro, 2014

23 Janeiro, 2014

20 Janeiro, 2014

17 Janeiro, 2014

16 Janeiro, 2014

16 Janeiro, 2014

15 Janeiro, 2014

15 Janeiro, 2014

14 Janeiro, 2014

29 Novembro, 2013

Para ver a publicação faça o seu Login ou Registe-se
23 Outubro, 2019
Nesta edição da revista Médico News, revisite os temas fortes da edição da 56.ª reunião da ASCO, que decorreu em Chicago de 31 de maio a 4 de junho. Ainda, conheça alguns dos novos ensaios, atualizações de guidelines e debates sobre insuficiência cardíaca, no dossiê dedicado ao Heart Failure 2019. realizado entre 25 a 28 de maio em Atenas.